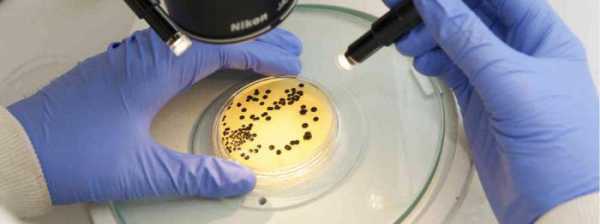

Вузы Санкт-Петербурга 2018 с ЕГЭ по биологии: специальности. Куда поступать?
closeДобавить вуз в сравнение
МГУ Московский государственный университет имени М.В. Ломоносова КФУ Казанский (Приволжский) федеральный университет УрФУ Уральский федеральный университет имени первого Президента России Б. Н. Ельцина РУДН Российский университет дружбы народов ДВФУ Дальневосточный федеральный университет МГТУ Московский государственный технический университет им. Н.Э. Баумана РГГУ Российский государственный гуманитарный университет РГУНиГ им. И.М. Губкина Российский государственный университет нефти и газа им. И.М. Губкина СПбГУ Санкт-Петербургский государственный университет ПМГМУ им. И.М. Сеченова Первый Московский государственный медицинский университет им. И.М.Сеченова ЮФУ Южный федеральный университет КубГУ Кубанский государственный университет РНИМУ им. Н.И. Пирогова Российский национальный исследовательский медицинский университет имени Н. И. Пирогова МГИМО Московский государственный институт международных отношений (Университет) МИД России МАИ Московский авиационный институт НИУ УдГУ Удмуртский государственный университет РАНХиГС Российская академия народного хозяйства и государственной службы при Президенте Российской Федерации ВГУ Воронежский государственный университет СПбПУ Санкт-Петербургский политехнический университет Петра Великого Горный университет Санкт-Петербургский Горный университет МосУ МВД РФ Московский университет Министерства внутренних дел Российской Федерации им. В.Я Кикотя СКФУ Северо-Кавказский федеральный университет МГЛУ Московский государственный лингвистический университет БГТУ ВОЕНМЕХ Балтийский государственный технический университет «ВОЕНМЕХ» имени Д. Ф. Устинова ДГТУ Донской государственный технический университет РЭУ им. Г. В. Плеханова Российский экономический университет имени Г.В. Плеханова ЮУрГУ Южно-Уральский государственный университет (национальный исследовательский университет) СПбГЭУ Санкт-Петербургский государственный экономический университет НИУ ВШЭ Высшая школа экономики НИУ МТУСИ Московский технический университет связи и информатики КНИТУ Казанский национальный исследовательский технологический университет ТюмГНГУ Тюменский государственный нефтегазовый университет (ныне Тюменский индустриальный университет) РУТ (МИИТ) Российский университет транспорта (МИИТ) СФУ Сибирский федеральный университет УГНТУ Уфимский государственный нефтяной технический университет ТюмГУ Тюменский государственный университет МПГУ Московский педагогический государственный университет МГПУ Московский городской педагогический университет ЛГУ им. Пушкина Ленинградский государственный университет имени А. С. Пушкина РГПУ Российский государственный педагогический университет имени А. И. Герцена СГУ им. Чернышевского Саратовский государственный университет имени Н.Г. Чернышевского РГСУ Российский государственный социальный университет НГТУ Новосибирский государственный технический университет ПГУ Пензенский государственный университет КубГАУ Кубанский государственный аграрный университет КубГТУ Кубанский государственный технологический университет ВУМО Военный университет Министерства обороны Российской Федерации Университет ИТМО Санкт-Петербургский национальный исследовательский университет информационных технологий, механики и оптики РГАУ-МСХА им. Тимирязева Российский государственный аграрный университет – МСХА имени К.А. Тимирязева ННГУ им. Лобачевского Нижегородский государственный университет им. Н.И. Лобачевского ПСПбГМУ им. Павлова Первый Санкт-Петербургский государственный медицинский университет имени академика И. П. Павлова СамГТУ Самарский государственный технический университет БелГУ Белгородский государственный национальный исследовательский университет РХТУ Российский химико-технологический университет им. Д.И. Менделеева ФУ Финансовый университет при Правительстве Российской Федерации МГМСУ им. А.И. Евдокимова Московский государственный медико-стоматологический университет БашГУ Башкирский государственный университет ОГУ Оренбургский государственный университет КГМУ Казанский государственный медицинский университет ИРНИТУ Иркутский национальный исследовательский технический университет МГХПА Московская государственная художественно-промышленная академия им. С. Г. Строганова Академия ФСБ Академия федеральной службы безопасности Российской Федерации СГАУ Самарский государственный аэрокосмический университет им. академика С.П. Королева (национальный исследовательский университет) САФУ Северный (Арктический) федеральный университет имени М.В. Ломоносова ВолГУ Волгоградский государственный университет ИГУ Иркутский государственный университет БФУ им. Канта Балтийский федеральный университет имени Иммануила Канта НИУ МГСУ Национальный исследовательский Московский государственный строительный университет УГАТУ Уфимский государственный авиационный технический университет АГЗ МЧС РФ Академия гражданской защиты МЧС России СПбГАСУ Санкт-Петербургский государственный архитектурно-строительный университет ВГАСУ Воронежский государственный архитектурно-строительный университет УрГПУ Уральский государственный педагогический университет ОмГУ Омский государственный университет им. Ф.М. Достоевского НИУ МИСиС Национальный исследовательский технологический университет «МИСиС» СГТУ Саратовский государственный технический университет им. Гагарина Ю.А. СамГУ Самарский государственный университет ОмГТУ Омский государственный технический университет НГМУ Новосибирский государственный медицинский университет КГАСУ Казанский государственный архитектурно-строительный университет МИРЭА, МГУПИ, МИТХТ Московский технологический университет ИжГТУ Ижевский государственный технический университет им. М.Т. Калашникова МГОУ Московский государственный областной университет НИУ МЭИ Национальный исследовательский университет «МЭИ» СПбУ МВД РФ Санкт-Петербургский университет Министерства внутренних дел РФ НГТУ им. Алексеева Нижегородский государственный технический университет им. Р.Е. Алексеева ДГУ Дагестанский государственный университет РГСУ Ростовский государственный строительный университет БГАУ Башкирский государственный аграрный университет МГУКИ Московский государственный университет культуры и искусств КубГМУ Кубанский государственный медицинский университет ВГТУ Воронежский государственный технический университет НГПУ Новосибирский государственный педагогический университет ВКА им. Можайского Военно-космическая академия имени А. Ф. Можайского ЧелГУ Челябинский государственный университет ТГУ Национальный исследовательский Томский государственный университет СГЮА Саратовская государственная юридическая академия МГППУ Московский государственный психолого-педагогический университет МГУТУ им. К.Г. Разумовского Московский государственный университет технологий и управления им. К.Г. Разумовского КемГУ Кемеровский государственный университет МГАХИ Московский государственный академический художественный институт им. В.И. Сурикова РГУПС Ростовский государственный университет путей сообщения ГУАП Санкт-Петербургский государственный университет аэрокосмического приборостроения КУ МВД РФ Краснодарский университет Министерства внутренних дел Российской Федерации МГЮА Московский государственный юридический университет имени О.Е. Кутафина СЗГМУ Северо-Западный государственный медицинский университет им. И. И. Мечникова АГУ Астраханский государственный университет КГЭУ Казанский государственный энергетический университет ЯрГУ Ярославский государственный университет имени П. Г. Демидова ВГПУ Воронежский государственный педагогический университет АлтГУ Алтайский государственный университет СПбГУТ Санкт-Петербургский государственный университет телекоммуникаций им. проф. М.А.Бонч-Бруевича СПбУГПС Санкт-Петербургский университет государственной противопожарной службы МЧС России РГЭУ (РИНХ) Ростовский государственный экономический университет (РИНХ) СПбУТУиЭ Санкт-Петербургский университет технологий управления и экономики ПГНИУ Пермский государственный национальный исследовательский университет УГЛТУ Уральский государственный лесотехнический университет РГУФКСМиТ Российский государственный университет физической культуры, спорта, молодежи и туризма ВГАУ Воронежский государственный аграрный университет им. императора Петра I ГУМРФ им. Макарова Государственный университет морского и речного флота имени адмирала С. О. Макарова МФТИ Московский физико-технический институт (Государственный университет) НГУ Новосибирский национальный исследовательский государственный университет РосНОУ Российский новый университет ВГУЭС Владивостокский государственный университет экономики и сервиса ВолгГМУ Волгоградский государственный медицинский университет РГУТиС Российский государственный университет туризма и сервиса НИЯУ МИФИ Национальный исследовательский ядерный университет «МИФИ» АлтГТУ Алтайский государственный технический университет им. И.И. Ползунова СПбГУГА Санкт-Петербургский государственный университет гражданской авиации ВятГУ Вятский государственный университет ПГУ Пятигорский государственный университет ОмГУПС Омский государственный университет путей сообщения СПбГЭТУ «ЛЭТИ» Санкт-Петербургский государственный электротехнический университет «ЛЭТИ» им. В.И. Ульянова (Ленина) ЯГПУ Ярославский государственный педагогический университет им. К.Д. Ушинского СамГМУ Самарский государственный медицинский университет СПбГАУ Санкт-Петербургский государственный аграрный университет МГТУ им. Носова Магнитогорский государственный технический университет им. Г.И. Носова БГПУ им. М. Акмуллы Башкирский государственный педагогический университет им. М. Акмуллы МФЮА Московский финансово-юридический университет СГМУ Саратовский государственный медицинский университет им. В.И. Разумовского ВИВВ МВД РФ Санкт-Петербургский военный институт внутренних войск МВД РФ КГИК Краснодарский государственный институт культуры РГППУ Российский государственный профессионально-педагогический университет МАДИ (ГТУ) Московский автомобильно-дорожный государственный технический университет АГТУ Астраханский государственный технический университет СПбГУП Санкт-Петербургский гуманитарный университет профсоюзов ОмГПУ Омский государственный педагогический университет ТПУ Национальный исследовательский Томский политехнический университет СПбГТИ Санкт-Петербургский государственный технологический институт (технический университет) МГАВМиБ им. К.И. Скрябина Московская государственная академия ветеринарной медицины и биотехнологии им. К.И. Скрябина УГМА Уральский государственный медицинский университет МАМИ Московский государственный машиностроительный университет ВГСПУ Волгоградский государственный социально-педагогический университет БГТУ им. В.Г. Шухова Белгородский государственный технологический университет им. В.Г. Шухова РостГМУ Ростовский государственный медицинский университет РТА Российская таможенная академия УрГЭУ Уральский государственный экономический университет ГУУ Государственный университет управления ВГУИТ Воронежский государственный университет инженерных технологий ВолгГТУ Волгоградский государственный технический университет СГАСУ Самарский государственный архитектурно-строительный университет ВАВТ Всероссийская академия внешней торговли Министерства экономического развития России ОрГМУ Оренбургская государственная медицинская академия ТГМУ Тихоокеанский государственный медицинский университет СибГТУ Сибирский государственный технологический университет ТюмГАСУ Тюменский государственный архитектурно-строительный университет СПбГТЭУ Санкт-Петербургский государственный торгово-экономический университет (часть СПбПУ) СПбГИК Санкт-Петербургский государственный институт культуры ЯГТУ Ярославский государственный технический университет Академия ФСИН Академия права и управления Федеральной службы исполнения наказаний ПГМУ Пермский государственный медицинский университет им. акад. Е.А. Вагнера КазГИК Казанский государственный институт культуры ДГПУ Дагестанский государственный педагогический университет СГУ Сочинский государственный университет СПбГЛТУ Санкт-Петербургский государственный лесотехнический университет им. С.М. Кирова ПГУПС Петербургский государственный университет путей сообщения императора Александра I УрГЮУ Уральский государственный юридический университет ННГАСУ Нижегородский государственный архитектурно-строительный университет ПНИПУ Пермский национальный исследовательский политехнический университет УГГУ Уральский государственный горный университет ЮРГПУ Южно-Российский государственный политехнический университет им. М.И. Платова ГУЗ Государственный университет по землеустройству РПА Минюста России Всероссийский государственный университет юстиции КрасГМУ Красноярский государственный медицинский университет им. проф. В.Ф. Войно-Ясенецкого НижГМА Нижегородская государственная медицинская академия Министерства здравоохранения и социального развития Российской Федерации УрГУПС Уральский государственный университет путей сообщения НГАУ Новосибирский государственный аграрный университет СГУПС Сибирский государственный университет путей сообщения РГУП Российский государственный университет правосудия РМАТ Российская международная академия туризма РАМ Российская академия музыки им. Гнесиных СПХФА Санкт-Петербургская государственная химико-фармацевтическая академия НА МВД РФ Нижегородская академия Министерства внутренних дел России КрасГАУ Красноярский государственный аграрный университет МАРХИ Московский архитектурный институт (Государственная академия) НГУЭУ Новосибирский государственный университет экономики и управления – “НИНХ” ВГИК Всероссийский государственный университет кинематографии имени С. А. Герасимова ЯГМУ Ярославский государственный медицинский университет РГУ Рязанский государственный университет им. С.А. Есенина АГМУ Алтайский государственный медицинский университет ГАУГН Государственный академический университет гуманитарных наук при Российской академии наук СПбГУПТД Санкт-Петербургский государственный университет промышленных технологий и дизайна СПбГПМУ Санкт-Петербургский государственный педиатрический медицинский университет ВолГАУ Волгоградский государственный аграрный университет СИ РАО Смольный институт Российской академии образования МГТУ “Станкин” Московский государственный технологический университет «Станкин» СибГМУ Сибирский государственный медицинский университет РязГМУ Рязанский государственный медицинский университет им. акад. И.П. Павлова ВАС им. Буденого Военная академия связи имени маршала Советского Союза С. М. Буденного МФПУ Синергия Университет СИНЕРГИЯ ДГМА Дагестанская государственная медицинская академия ВГМА им. Бурденко Воронежская государственная медицинская академия ПГГПУ Пермский государственный гуманитарно-педагогический университет СибГУТИ Сибирский государственный университет телекоммуникаций и информатики МГУЛ Московский государственный университет леса МГУДТ Московский государственный университет дизайна и технологии ВИ МВД РФ Воронежский институт МВД России КГПУ Красноярский государственный педагогический университет им. В.П. Астафьева МИЭТ Национальный исследовательский университет «МИЭТ» СмолГУ Смоленский государственный университет ИГМУ Иркутский государственный медицинский университет СГАУ Саратовский государственный аграрный университет им. Н.И. Вавилова МГУ Морской государственный университет им. адм. Г.И. Невельского АГАУ Алтайский государственный аграрный университет СПбГАВМ Санкт-Петербургская государственная академия ветеринарной медицины ГИТР Гуманитарный институт телевидения и радиовещания им. М.А. Литовчина ИЭУП Казанский инновационный университет имени В.Г. Тимитясова КузГТУ им. Горбачева Кузбасский государственный технический университет СибАДИ Сибирский государственный автомобильно-дорожный университет ТГУ Тольяттинский государственный университет СПбГМТУ Санкт-Петербургский государственный морской технический университет “Корабелка” СГЭУ Самарский государственный экономический университет Тюменский ГМУ Тюменский государственный медицинский университет ВИТИ Военный инженерно-технический институт Военной академии материально-технического обеспечения имени генерала армии А. В. Хрулева “ТИСБИ” Университет управления “ТИСБИ” СЮИ ФСИН РФ Самарский юридический институт ФСИН России МГТУГА Московский государственный технический университет гражданской авиации НГЛУ Нижегородский государственный лингвистический университет им. Н.А. Добролюбова БГУ Байкальский государственный университет МИИГАиК Московский государственный университет геодезии и картографии ИжГСХА Ижевская государственная сельскохозяйственная академия ВВА Военно-воздушная академия им. проф. Н.Е. Жуковского и Ю.А. Гагарина ИГМА Ижевская государственная медицинская академия РГРТУ Рязанский государственный радиотехнический университет УрГАУ Уральский государственный аграрный университет БГМУ Минздрава России Башкирский государственный медицинский университет НВВКУ Новосибирское высшее военное командное училище Университет «Дубна» Государственный университет «Дубна» КГТУ Калининградский государственный технический университет СГМУ Северный государственный медицинский университет ОмГМУ Омский государственный медицинский университет КГУФКСТ Кубанский государственный университет физической культуры, спорта и туризма УИ ГПС МЧС России Уральский институт Государственной противопожарной службы МЧС России КГАУ Казанский государственный аграрный университет БАТиП Балтийская академия туризма и предпринимательства Астраханский ГМУ Астраханский государственный медицинский университет ТГИК Тюменский государственный институт культуры СИБУПК Сибирский университет потребительской кооперации МИТХТ Московский государственный университет тонких химических технологий имени М.В. Ломоносова Поволжская ГАФКСиТ Поволжская государственная академия физической культуры, спорта и туризма ВАМТОВузы Челябинска 2018 с ЕГЭ по биологии: специальности. Куда поступать?
closeДобавить вуз в сравнение
МГУ Московский государственный университет имени М.В. Ломоносова КФУ Казанский (Приволжский) федеральный университет УрФУ Уральский федеральный университет имени первого Президента России Б. Н. Ельцина РУДН Российский университет дружбы народов ДВФУ Дальневосточный федеральный университет МГТУ Московский государственный технический университет им. Н.Э. Баумана РГГУ Российский государственный гуманитарный университет РГУНиГ им. И.М. Губкина Российский государственный университет нефти и газа им. И.М. Губкина СПбГУ Санкт-Петербургский государственный университет ПМГМУ им. И.М. Сеченова Первый Московский государственный медицинский университет им. И.М.Сеченова ЮФУ Южный федеральный университет КубГУ Кубанский государственный университет РНИМУ им. Н.И. Пирогова Российский национальный исследовательский медицинский университет имени Н. И. Пирогова МГИМО Московский государственный институт международных отношений (Университет) МИД России МАИ Московский авиационный институт НИУ УдГУ Удмуртский государственный университет РАНХиГС Российская академия народного хозяйства и государственной службы при Президенте Российской Федерации ВГУ Воронежский государственный университет СПбПУ Санкт-Петербургский политехнический университет Петра Великого Горный университет Санкт-Петербургский Горный университет МосУ МВД РФ Московский университет Министерства внутренних дел Российской Федерации им. В.Я Кикотя СКФУ Северо-Кавказский федеральный университет МГЛУ Московский государственный лингвистический университет БГТУ ВОЕНМЕХ Балтийский государственный технический университет «ВОЕНМЕХ» имени Д. Ф. Устинова ДГТУ Донской государственный технический университет РЭУ им. Г. В. Плеханова Российский экономический университет имени Г.В. Плеханова ЮУрГУ Южно-Уральский государственный университет (национальный исследовательский университет) СПбГЭУ Санкт-Петербургский государственный экономический университет НИУ ВШЭ Высшая школа экономики НИУ МТУСИ Московский технический университет связи и информатики КНИТУ Казанский национальный исследовательский технологический университет ТюмГНГУ Тюменский государственный нефтегазовый университет (ныне Тюменский индустриальный университет) РУТ (МИИТ) Российский университет транспорта (МИИТ) СФУ Сибирский федеральный университет УГНТУ Уфимский государственный нефтяной технический университет ТюмГУ Тюменский государственный университет МПГУ Московский педагогический государственный университет МГПУ Московский городской педагогический университет ЛГУ им. Пушкина Ленинградский государственный университет имени А. С. Пушкина РГПУ Российский государственный педагогический университет имени А. И. Герцена СГУ им. Чернышевского Саратовский государственный университет имени Н.Г. Чернышевского РГСУ Российский государственный социальный университет НГТУ Новосибирский государственный технический университет ПГУ Пензенский государственный университет КубГАУ Кубанский государственный аграрный университет КубГТУ Кубанский государственный технологический университет ВУМО Военный университет Министерства обороны Российской Федерации Университет ИТМО Санкт-Петербургский национальный исследовательский университет информационных технологий, механики и оптики РГАУ-МСХА им. Тимирязева Российский государственный аграрный университет – МСХА имени К.А. Тимирязева ННГУ им. Лобачевского Нижегородский государственный университет им. Н.И. Лобачевского ПСПбГМУ им. Павлова Первый Санкт-Петербургский государственный медицинский университет имени академика И. П. Павлова СамГТУ Самарский государственный технический университет БелГУ Белгородский государственный национальный исследовательский университет РХТУ Российский химико-технологический университет им. Д.И. Менделеева ФУ Финансовый университет при Правительстве Российской Федерации МГМСУ им. А.И. Евдокимова Московский государственный медико-стоматологический университет БашГУ Башкирский государственный университет ОГУ Оренбургский государственный университет КГМУ Казанский государственный медицинский университет ИРНИТУ Иркутский национальный исследовательский технический университет МГХПА Московская государственная художественно-промышленная академия им. С. Г. Строганова Академия ФСБ Академия федеральной службы безопасности Российской Федерации СГАУ Самарский государственный аэрокосмический университет им. академика С.П. Королева (национальный исследовательский университет) САФУ Северный (Арктический) федеральный университет имени М.В. Ломоносова ВолГУ Волгоградский государственный университет ИГУ Иркутский государственный университет БФУ им. Канта Балтийский федеральный университет имени Иммануила Канта НИУ МГСУ Национальный исследовательский Московский государственный строительный университет УГАТУ Уфимский государственный авиационный технический университет АГЗ МЧС РФ Академия гражданской защиты МЧС России СПбГАСУ Санкт-Петербургский государственный архитектурно-строительный университет ВГАСУ Воронежский государственный архитектурно-строительный университет УрГПУ Уральский государственный педагогический университет ОмГУ Омский государственный университет им. Ф.М. Достоевского НИУ МИСиС Национальный исследовательский технологический университет «МИСиС» СГТУ Саратовский государственный технический университет им. Гагарина Ю.А. СамГУ Самарский государственный университет ОмГТУ Омский государственный технический университет НГМУ Новосибирский государственный медицинский университет КГАСУ Казанский государственный архитектурно-строительный университет МИРЭА, МГУПИ, МИТХТ Московский технологический университет ИжГТУ Ижевский государственный технический университет им. М.Т. Калашникова МГОУ Московский государственный областной университет НИУ МЭИ Национальный исследовательский университет «МЭИ» СПбУ МВД РФ Санкт-Петербургский университет Министерства внутренних дел РФ НГТУ им. Алексеева Нижегородский государственный технический университет им. Р.Е. Алексеева ДГУ Дагестанский государственный университет РГСУ Ростовский государственный строительный университет БГАУ Башкирский государственный аграрный университет МГУКИ Московский государственный университет культуры и искусств КубГМУ Кубанский государственный медицинский университет ВГТУ Воронежский государственный технический университет НГПУ Новосибирский государственный педагогический университет ВКА им. Можайского Военно-космическая академия имени А. Ф. Можайского ЧелГУ Челябинский государственный университет ТГУ Национальный исследовательский Томский государственный университет СГЮА Саратовская государственная юридическая академия МГППУ Московский государственный психолого-педагогический университет МГУТУ им. К.Г. Разумовского Московский государственный университет технологий и управления им. К.Г. Разумовского КемГУ Кемеровский государственный университет МГАХИ Московский государственный академический художественный институт им. В.И. Сурикова РГУПС Ростовский государственный университет путей сообщения ГУАП Санкт-Петербургский государственный университет аэрокосмического приборостроения КУ МВД РФ Краснодарский университет Министерства внутренних дел Российской Федерации МГЮА Московский государственный юридический университет имени О.Е. Кутафина СЗГМУ Северо-Западный государственный медицинский университет им. И. И. Мечникова АГУ Астраханский государственный университет КГЭУ Казанский государственный энергетический университет ЯрГУ Ярославский государственный университет имени П. Г. Демидова ВГПУ Воронежский государственный педагогический университет АлтГУ Алтайский государственный университет СПбГУТ Санкт-Петербургский государственный университет телекоммуникаций им. проф. М.А.Бонч-Бруевича СПбУГПС Санкт-Петербургский университет государственной противопожарной службы МЧС России РГЭУ (РИНХ) Ростовский государственный экономический университет (РИНХ) СПбУТУиЭ Санкт-Петербургский университет технологий управления и экономики ПГНИУ Пермский государственный национальный исследовательский университет УГЛТУ Уральский государственный лесотехнический университет РГУФКСМиТ Российский государственный университет физической культуры, спорта, молодежи и туризма ВГАУ Воронежский государственный аграрный университет им. императора Петра I ГУМРФ им. Макарова Государственный университет морского и речного флота имени адмирала С. О. Макарова МФТИ Московский физико-технический институт (Государственный университет) НГУ Новосибирский национальный исследовательский государственный университет РосНОУ Российский новый университет ВГУЭС Владивостокский государственный университет экономики и сервиса ВолгГМУ Волгоградский государственный медицинский университет РГУТиС Российский государственный университет туризма и сервиса НИЯУ МИФИ Национальный исследовательский ядерный университет «МИФИ» АлтГТУ Алтайский государственный технический университет им. И.И. Ползунова СПбГУГА Санкт-Петербургский государственный университет гражданской авиации ВятГУ Вятский государственный университет ПГУ Пятигорский государственный университет ОмГУПС Омский государственный университет путей сообщения СПбГЭТУ «ЛЭТИ» Санкт-Петербургский государственный электротехнический университет «ЛЭТИ» им. В.И. Ульянова (Ленина) ЯГПУ Ярославский государственный педагогический университет им. К.Д. Ушинского СамГМУ Самарский государственный медицинский университет СПбГАУ Санкт-Петербургский государственный аграрный университет МГТУ им. Носова Магнитогорский государственный технический университет им. Г.И. Носова БГПУ им. М. Акмуллы Башкирский государственный педагогический университет им. М. Акмуллы МФЮА Московский финансово-юридический университет СГМУ Саратовский государственный медицинский университет им. В.И. Разумовского ВИВВ МВД РФ Санкт-Петербургский военный институт внутренних войск МВД РФ КГИК Краснодарский государственный институт культуры РГППУ Российский государственный профессионально-педагогический университет МАДИ (ГТУ) Московский автомобильно-дорожный государственный технический университет АГТУ Астраханский государственный технический университет СПбГУП Санкт-Петербургский гуманитарный университет профсоюзов ОмГПУ Омский государственный педагогический университет ТПУ Национальный исследовательский Томский политехнический университет СПбГТИ Санкт-Петербургский государственный технологический институт (технический университет) МГАВМиБ им. К.И. Скрябина Московская государственная академия ветеринарной медицины и биотехнологии им. К.И. Скрябина УГМА Уральский государственный медицинский университет МАМИ Московский государственный машиностроительный университет ВГСПУ Волгоградский государственный социально-педагогический университет БГТУ им. В.Г. Шухова Белгородский государственный технологический университет им. В.Г. Шухова РостГМУ Ростовский государственный медицинский университет РТА Российская таможенная академия УрГЭУ Уральский государственный экономический университет ГУУ Государственный университет управления ВГУИТ Воронежский государственный университет инженерных технологий ВолгГТУ Волгоградский государственный технический университет СГАСУ Самарский государственный архитектурно-строительный университет ВАВТ Всероссийская академия внешней торговли Министерства экономического развития России ОрГМУ Оренбургская государственная медицинская академия ТГМУ Тихоокеанский государственный медицинский университет СибГТУ Сибирский государственный технологический университет ТюмГАСУ Тюменский государственный архитектурно-строительный университет СПбГТЭУ Санкт-Петербургский государственный торгово-экономический университет (часть СПбПУ) СПбГИК Санкт-Петербургский государственный институт культуры ЯГТУ Ярославский государственный технический университет Академия ФСИН Академия права и управления Федеральной службы исполнения наказаний ПГМУ Пермский государственный медицинский университет им. акад. Е.А. Вагнера КазГИК Казанский государственный институт культуры ДГПУ Дагестанский государственный педагогический университет СГУ Сочинский государственный университет СПбГЛТУ Санкт-Петербургский государственный лесотехнический университет им. С.М. Кирова ПГУПС Петербургский государственный университет путей сообщения императора Александра I УрГЮУ Уральский государственный юридический университет ННГАСУ Нижегородский государственный архитектурно-строительный университет ПНИПУ Пермский национальный исследовательский политехнический университет УГГУ Уральский государственный горный университет ЮРГПУ Южно-Российский государственный политехнический университет им. М.И. Платова ГУЗ Государственный университет по землеустройству РПА Минюста России Всероссийский государственный университет юстиции КрасГМУ Красноярский государственный медицинский университет им. проф. В.Ф. Войно-Ясенецкого НижГМА Нижегородская государственная медицинская академия Министерства здравоохранения и социального развития Российской Федерации УрГУПС Уральский государственный университет путей сообщения НГАУ Новосибирский государственный аграрный университет СГУПС Сибирский государственный университет путей сообщения РГУП Российский государственный университет правосудия РМАТ Российская международная академия туризма РАМ Российская академия музыки им. Гнесиных СПХФА Санкт-Петербургская государственная химико-фармацевтическая академия НА МВД РФ Нижегородская академия Министерства внутренних дел России КрасГАУ Красноярский государственный аграрный университет МАРХИ Московский архитектурный институт (Государственная академия) НГУЭУ Новосибирский государственный университет экономики и управления – “НИНХ” ВГИК Всероссийский государственный университет кинематографии имени С. А. Герасимова ЯГМУ Ярославский государственный медицинский университет РГУ Рязанский государственный университет им. С.А. Есенина АГМУ Алтайский государственный медицинский университет ГАУГН Государственный академический университет гуманитарных наук при Российской академии наук СПбГУПТД Санкт-Петербургский государственный университет промышленных технологий и дизайна СПбГПМУ Санкт-Петербургский государственный педиатрический медицинский университет ВолГАУ Волгоградский государственный аграрный университет СИ РАО Смольный институт Российской академии образования МГТУ “Станкин” Московский государственный технологический университет «Станкин» СибГМУ Сибирский государственный медицинский университет РязГМУ Рязанский государственный медицинский университет им. акад. И.П. Павлова ВАС им. Буденого Военная академия связи имени маршала Советского Союза С. М. Буденного МФПУ Синергия Университет СИНЕРГИЯ ДГМА Дагестанская государственная медицинская академия ВГМА им. Бурденко Воронежская государственная медицинская академия ПГГПУ Пермский государственный гуманитарно-педагогический университет СибГУТИ Сибирский государственный университет телекоммуникаций и информатики МГУЛ Московский государственный университет леса МГУДТ Московский государственный университет дизайна и технологии ВИ МВД РФ Воронежский институт МВД России КГПУ Красноярский государственный педагогический университет им. В.П. Астафьева МИЭТ Национальный исследовательский университет «МИЭТ» СмолГУ Смоленский государственный университет ИГМУ Иркутский государственный медицинский университет СГАУ Саратовский государственный аграрный университет им. Н.И. Вавилова МГУ Морской государственный университет им. адм. Г.И. Невельского АГАУ Алтайский государственный аграрный университет СПбГАВМ Санкт-Петербургская государственная академия ветеринарной медицины ГИТР Гуманитарный институт телевидения и радиовещания им. М.А. Литовчина ИЭУП Казанский инновационный университет имени В.Г. Тимитясова КузГТУ им. Горбачева Кузбасский государственный технический университет СибАДИ Сибирский государственный автомобильно-дорожный университет ТГУ Тольяттинский государственный университет СПбГМТУ Санкт-Петербургский государственный морской технический университет “Корабелка” СГЭУ Самарский государственный экономический университет Тюменский ГМУ Тюменский государственный медицинский университет ВИТИ Военный инженерно-технический институт Военной академии материально-технического обеспечения имени генерала армии А. В. Хрулева “ТИСБИ” Университет управления “ТИСБИ” СЮИ ФСИН РФ Самарский юридический институт ФСИН России МГТУГА Московский государственный технический университет гражданской авиации НГЛУ Нижегородский государственный лингвистический университет им. Н.А. Добролюбова БГУ Байкальский государственный университет МИИГАиК Московский государственный университет геодезии и картографии ИжГСХА Ижевская государственная сельскохозяйственная академия ВВА Военно-воздушная академия им. проф. Н.Е. Жуковского и Ю.А. Гагарина ИГМА Ижевская государственная медицинская академия РГРТУ Рязанский государственный радиотехнический университет УрГАУ Уральский государственный аграрный университет БГМУ Минздрава России Башкирский государственный медицинский университет НВВКУ Новосибирское высшее военное командное училище Университет «Дубна» Государственный университет «Дубна» КГТУ Калининградский государственный технический университет СГМУ Северный государственный медицинский университет ОмГМУ Омский государственный медицинский университет КГУФКСТ Кубанский государственный университет физической культуры, спорта и туризма УИ ГПС МЧС России Уральский институт Государственной противопожарной службы МЧС России КГАУ Казанский государственный аграрный университет БАТиП Балтийская академия туризма и предпринимательства Астраханский ГМУ Астраханский государственный медицинский университет ТГИК Тюменский государственный институт культуры СИБУПК Сибирский университет потребительской кооперации МИТХТ Московский государственный университет тонких химических технологий имени М.В. Ломоносова Поволжская ГАФКСиТ Поволжская государственная академия физической культуры, спорта и туризма ВАМТО Военная академия материально-технического обеспечения им. генерала армии А.В. Хрулёва ГИТИС Российский институт театрального искусства КГМА Кировская государственная медицинская академия ВГУВТ Волжский государственный университет водного транспорта СтГАУ Ставропольский государственный аграрный университет РГГМУ Российский государственный гидрометеорологический университет ВИ ФСИН Воронежский институт федеральной службы исполнения наказаний Российской Федерации СПбГИКиТ Санкт-Петербургский государственный институт кино и телевидения ОГПУ Оренбургский государственный педагогический университет ОГАУ Оренбургский государственный аграрный университет НГПУ Нижегородский государственный педагогический университет им. Козьмы Минина ОГИС Омский государственный институт сервиса РАЖВиЗ Российская академия живописи, ваяния и зодчества Ильи Глазунова АГПА Армавирская государственная педагогическая академия НВИ ВВ МВД РФ Новосибирский военный институт внутренних войск МВД России имени генерала армии И.К. Яковлева ТУСУР Томский государственный университет систем управления и радиоэлектроники НГСХА Нижегородская государственная сельскохозяйственная академия МПИ ФСБ РФ Московский пограничный институт Федеральной службы безопасности Российской Федерации Филиал РАНХиГС в Санкт-Петербурге Северо-Западный институт управления РАНХиГС НЧФ КФУ Набережночелнинский институт КФУ (филиал) ТГАСУ Томский государственный архитектурно-строительный университет МГУП Московский государственный университет печати им. Ивана Федорова Московский политех Московский политехнический университет МосГУ Московский гуманитарный университет АлтГПУ Алтайский государственный педагогический университет СтГМУ Ставропольский государственный медицинский университет НИУ ВШЭ Санкт-Петербург Санкт-Петербургский кампус Национального исследовательского университета «Высшая школа экономики» ВА МВД РФ Волгоградская академия МВД России Академия ГПС МЧС России Академия государственной противопожарной службы Министерства Российской Федерации по делам гражданской обороны, чрезвычайным ситуациям и ликвидации последствий стихийных бедствий ВМА им. Кузнецова Военно-морская академия имени адмирала флота Советского Союза Н. Г. Кузнецова МВАА Михайловская военная артиллерийская академия ОмГАУ Омский государственный аграрный университет им. П.А. Столыпина ПГУТИ Поволжский государственный университет телекоммуникаций и информатики НГПУ Набережночелнинский государственный педагогический университет ВолгГАСУ Волгоградский государственный архитектурно-строительный университет МГГЭУ Московский государственный гуманитарно-экономический университет МХАТ Школа-студия (институт) им. Вл. И. Немировича-Данченко при МХАТ им. А. П. Чехова СГПИ Ставропольский государственный педагогический институт Саратовский социально-экономический институт (филиал) РЭУ им. Г.В. Плеханова Саратовский социально-экономический институт (филиал) Российского экономического университета имени Г.В. Плеханова ВГЛТУ Воронежский государственный лесотехнический университет ЮУГМУ Южно-Уральский государственный медицинский университет СамГУПС Самарский государственный университет путей сообщения ПГУАС Пензенский государственный университет архитектуры и строительства МГОСГИ Московский государственный областной социально-гуманитарный институт ГКА Государственная классическая академия им. Маймонида ГАУ Государственный аграрный университет Северного Зауралья ВятГГУ Вятский государственный гуманитарный университет ВА МТО им. Хрулева Военный институт (железнодорожных войск и военных сообщений) Военной академии материально-технического обеспечения им. Хрулева Севастопольский филиал МГУ Севастопольский филиал Московского государственного университета имени М.В. Ломоносова МГОГИ Московский государственный областной гуманитарный институт СГУГиТ Сибирский государственный университет геосистем и технологий ГМУ Государственный морской университет им. адм. Ф.Ф. Ушакова ДГАУ Донской государственный аграрный университет Дальрыбвтуз Дальневосточный государственный технический рыбохозяйственный университет СГМУ Минздрава Смоленский государственный медицинский университет Министерства здравоохранения Российской Федерации МГИИТ Московский Государственный Институт Индустрии Туризма имени Ю.А.Сенкевича ТГПУ Томский государственный педагогический университет НГУ Национальный государственный университет физической культуры, cпорта и здоровья имени П. Ф. Лесгафта КемТИПП Кемеровский технологический институт пищевой промышленности (университет) ПГФА Пермская государственная фармацевтическая академия ВАРВСН Военная академия ракетных войск стратегического назначения им. Петра Великого СГУВТ Сибирский государственный университет водного транспортаvuzopedia.ru
Куда можно поступить, сдавая химию и биологию?
Содержание статьи:
- Медицинский факультет
- Биологический факультет
- Факультет психологии
- Куда ещё можно поступить?

Медицинский факультет
Профессия популярна и востребована, поэтому без работы точно не останетесь. Чтобы стать хорошим врачом, нужно иметь терпение и огромное желание связать жизнь с медициной. Учтите, что придётся много учиться, зубрить, полностью отдаваться науке.
Для поступления потребуется высокий балл ЕГЭ. Выбирать придётся из разных специальностей:
- Анестезиолог — обеспечивает безопасность здоровья пациента во время проведения операции. Определяет оптимальный вид анестезии, контролирует работу жизненно важных органов. Выпускники данной профессии всегда востребованы.
- Стоматолог, стоматолог-ортопед. Окончив ВУЗ и набравшись опыта в стоматологии как второй врач или помощник, вы сможете самостоятельно принимать пациентов. В дальнейшем появится шанс открыть собственный стоматологический кабинет. Услуги грамотных специалистов оплачиваются неплохо.
- Фармацевт. Нет, вы не будете продавать лекарства. Ну, может, только первое время. Если строить карьеру в аптеке, можно дорасти до заведующего. Второй вариант — подать заявление в фармацевтическую компанию (некоторые зарубежные организации заинтересованы в молодых кадрах). Третий — пойти в науку, где можно заниматься разработкой новых лекарств.
- Косметолог. С этой профессией можно пойти работать в салон красоты, а не только в больницу.
Биологический факультет
Биология – важный предмет в жизни человека, поэтому специалисты данной области не менее востребованы. Для поступления понадобятся хорошие результаты не только биологии и химии, но и обязательным предметам (русский, математика).
Дополнительное преимущество имеют абитуриенты, которые разбираются в физике, но требование не обязательно. Способности можно подтянуть до необходимого уровня при прохождении обучения на первых курсах.
Возможно обучение в следующих направлениях:
- Антропология или палеонтология – имеет несколько научных отраслей, связанных с изучением происхождения и современного состояния человечества. Полученные знания используются во многих областях науки: медицине, инженерной психологии, психологии и так далее. Сфера деятельности очень интересная, правда найти работу с такой специальностью непросто.
- Генетика — если вам интересны рецессивные и доминантные гены, наследственность, смело поступайте на данное направление. В дальнейшем можете стать генетическим консультантом, генным инженером.
- Зоология – наука, направленная на изучение мира животных. Она пересекается с анатомией, эмбриологией, экологией и другими отраслями. Специалист занимается наблюдением за жизнедеятельностью особей, используя технологии (видеокамеры, фотоаппараты, средства аудиозаписи). Он проводит эксперименты в лабораториях и исследуют поведение животных в разных условиях.
- Биофизика – вид деятельности, подразумевающий изучение влияния на организм различных физических факторов (невесомость, ускорение, излучение). Он занимается исследованием и должен уметь пользоваться аппаратурой для проведения экспериментов.
- Почвоведение – специалисты данной области разрабатывают и организуют мероприятия, направленные на сохранение и повышение плодородности почв. Они составляют характеристики исследуемого объекта, контролируют качество и своевременность выполнения анализов.
- Биотехнология – подходит для тех, кто интересуется научной деятельностью в сфере биолого-технологических наук и желает использовать свои способности на практике. Специалист контролирует процесс изготовления препаратов, клеток различных микроорганизмов и прочей продукции, необходимой для медицины, пищевой промышленности, сельскохозяйственной деятельности.
Факультет психологии
Психология – интересная наука, охватывающая разные сферы деятельности человека. Студенты должны иметь знания в области медицины, понимать работу ЦНС и основы нейрофизиологии. Специальности могут быть такими:
Спортивный психолог – изучает психическое состояние человека во время движения, тренировок и другой деятельности, связанной со спортом. Специалист выявляет, как различные психологические факторы отражаются на результаты соревнований.
- Социальный педагог – помогает детям адаптироваться в современном обществе, сопротивляться дезорганизующимся условиям, занять достойное место в коллективе и при этом оставаться собой. Он работает с детьми из неблагополучных семей и ведёт профилактику правонарушений.
- Военный психолог – занимается изучением психологических проблем, возникающих при подготовке военнослужащих или выполнения боевых действий. Потребуется изучение большого количества дисциплин из разных областей: психодиагностика, реабилитация, противодействие соперникам и другие.
- Практическая психология – ориентирована на оказание помощи людям в виде консультаций, проведения треннингов. Требуются база определённых знаний, но основная задача – применение методов академической науки в жизни.
Обязательно узнавайте требования институтов, поскольку в некоторых из них для зачисления вместо химии нужна история.
Куда ещё можно поступить?
Если вас не привлекают перечисленные специальности, с ЕГЭ по химии и биологии позволяют стать:
- Агрономом. В трудовые обязанности войдет изучение почвы на определенных участках, помощь в проведении сельскохозяйственных работ, анализ собранного урожая.
- Биоинженером. По сути это профессия будущего. Немногие заведения готовят специалистов данного направления, но прогнозы говорят о том, что в ближайшие годы рассматриваемый вид деятельности станет востребованным.
- Ветеринаром. Конечно, это тоже медицина. Однако работать придётся с животными. На многих фермах требуются квалифицированные врачи. Можно работать в государственных или частных ветеринарных клиниках, либо открыть собственную организацию.
- Педагогом. С данными экзаменами можно поступить в педагогический ВУЗ и стать преподавателем химии и биологии, либо одной из наук.
- Физиологом. Вам предстоит изучать жизнедеятельность организмов, совместно с психологом проводить анализ влияния условий труда на организм работников предприятия.
- Биотехнологом. Сфера деятельности охватывает генетику, медицину, микробиологию, фармацевтику. Специалисты данного направления довольно востребованы и высоко ценятся на любом производстве, будь то пищевая промышленность, косметическая или производство парфюмерии.
- Зоопсихологом — специфическая деятельность. Если вы любите животных и вам интересно, как найти к ним подход, учитесь. В дальнейшем можно устроиться в частную ветеринарную клинику или работать дрессировщиком. Сюда же можно отнести кинологов, орнитологов, охотоведов.
Какую бы профессию вы не выбрали, учёба и работа будут тесно связаны с наукой. Хотите помогать людям, проводить лабораторные исследования и анализировать полученные результаты? Чувствуете, что вам это по душе? Тогда дерзайте!
love-mother.ru
Куда поступить с биологией и химией выпускникам школ и колледжей
Эту статью стоит обязательно прочитать тем, кто является выпускником старшей или средней школы, прекрасно знает химию и биологию, а также хочет, чтобы эти две дисциплины (или хотя бы одна из них) стали частью будущей профессии.

Так вы сможете определиться, какое направление выбрать, так как специальностей, связанных с химией и биологией, очень много в различных сферах. Очень важно выбрать именно ту деятельность, которая вам будет нравиться, ведь от каждого работника, связанного с этими дисциплинами, как правило, ожидают ответственности, аккуратности, эрудиции и смекалки. Заодно перечислим, куда поступить с биологией и химией.
Биологическое направление
Со знанием биологии можно работать в сфере флоры, изучать растительный мир, сельское хозяйство. В настоящее время наука популярна в направлении генной инженерии, изучении биологических процессов в живой природе. Не отстает в популярности экология. Если вы сдаете или уже сдали ЕГЭ, но не знаете, куда поступить с химией и биологией, то можете рассмотреть такие варианты:
- ботаника;
- зоология;
- агрономия;
- экология;
- психология;
- педагогика.
Существуют и другие направления, которые связаны с перечисленными выше.
Деятельность в области химии
Химические процессы можно наблюдать всюду: и в природе, и в технике, и в медицине, даже косметология не обходится без данной науки. Но куда поступить с биологией и химией, чтобы большее внимание уделялось именно химии?
Химик, как правило, основную часть времени проводит в лаборатории. Он может заниматься химическими или медицинскими исследованиями, изучать технологию изготовления различных материалов, заниматься исследованиями в сфере окружающей среды.
Нужна ли биохимия?
Но бывает и так, что школьник прекрасно знает и любит оба предмета: химию и биологию. Разумеется, у него есть все шансы стать прекрасным специалистом. Но кто должен отлично знать эти две науки? Давайте перечислим:
- врачи;
- провизоры;
- биохимики.
Биология и химии позволяют изучать живые организмы в условиях лаборатории, исследовать все химические и биологические процессы, происходящие в теле человека, животного. Нередко специалисты изучают и микромир: вирусы, бактерии, грибки и паразитов.
Какие вузы принимают абитуриентов со знанием химии и биологии?
Вы успешно сдали ЕГЭ (русский, химию, биологию), куда поступить – не знаете?

В таком случае ориентируйтесь на следующие профили институтов:
- медицинские;
- педагогические;
- многопрофильные (там наверняка будет подходящий факультет).
Например, вы можете поступить в Москве в:
- ММА им. Сеченова.
- МГУ им. Ломоносова.
- РУДН.
Также можно выбрать аграрный университет или технический, если есть интерес к сельскому хозяйству или технике.
Какие специальности существуют?
Куда поступить с биологией и химией? Этот вопрос мы рассмотрели ранее. Теперь кратко перечислим, какие специальности отвечают этим направлениям:
- биолог;
- химик;
- биохимик;
- эколог;
- агроном;
- генетик;
- инженер;
- микробиолог.
Есть и другие квалификации, которые могут отличаться узкопрофильным направлением.
Кем можно работать?
Выпускники школ и их родители задаются вопросом, кем можно работать с биологией и химией, куда можно поступить. Как мы уже рассмотрели выше, выбор достаточно широкий. Если человек умеет объяснять простые и сложные вещи, проводить элементарные опыты, делиться своими знаниями с аудиторией, то рекомендуется выбрать педагогическую деятельность с возможностью поступления в аспирантуру.

Если есть интерес к медицине, есть желание изучать все, что происходит в организме человека или животного, то можно выбрать биохимию, чтобы работать в лаборатории, проводить различные анализы.
Любителям сельской жизни, природы также можно проводить химические исследования, изучать живой и неживой мир.
Тем, кто любит исследовать что-то, самостоятельно докапываться до истины, лучше рассматривать научно-исследовательские лаборатории по созданию новых препаратов, бытовой химии или различных косметических средств.
Перспективная ли работа?
Подобный вопрос чаще волнует родителей. Трудно однозначно сказать, есть ли карьерный рост, какие-либо перспективы. Зачастую все зависит от самого человека, его личных качеств и профессионализма. Если он желает учиться, развиваться, при необходимости изучать, например, иностранные языки, чтобы выезжать на конференции или в командировки в другие страны, то, безусловно, его профессия перспективна. Такая деятельность не только принесет хороший доход, но и поможет развиваться науке, окружающему миру.
Чем можно заниматься самостоятельно?
Иногда бывает так, что взрослый человек, отработавший какое-то время на предприятии, понял, что есть желание открыть собственную лабораторию для исследований или проводить различные семинары, тренинги, но не хватает знаний и навыков.

Затем задается вопросом о том, куда можно поступить, сдавая химию и биологию. Что можно предложить? Например:
- проведение психологических тренингов и консультаций;
- самостоятельные исследования в области биохимии;
- репетиторство;
- изучение наук с целью написания статей, блогов, книг.
Чтобы самому заниматься химией и биологией, нужно вложить средства в покупку оборудования, расходных материалов и инструментов.
Минусы для тех, кто хорошо знает химию и биологию
Недостатком деятельности практически для всех химиков и биохимиков является то, что работа проходит с вредными и даже опасными веществами. Если у научного сотрудника есть предрасположенность к аллергии, имеются сопутствующие заболевания, слабый иммунитет, то в подобную сферу лучше не идти вообще. Но если со здоровьем все в порядке, то смело можно спрашивать, куда поступить с биологией и химией. Выбирать есть из чего: подходящие факультеты есть в медицинских, аграрных, технических и педагогических вузах.
Нужно помнить, что работа подобных специалистов является вредной, состояние здоровья может ухудшиться, поэтому рекомендуется заранее ознакомиться с будущей профессией.
fb.ru
Вузы Самары 2018 с ЕГЭ по биологии: специальности. Куда поступать?
closeДобавить вуз в сравнение
МГУ Московский государственный университет имени М.В. Ломоносова КФУ Казанский (Приволжский) федеральный университет УрФУ Уральский федеральный университет имени первого Президента России Б. Н. Ельцина РУДН Российский университет дружбы народов ДВФУ Дальневосточный федеральный университет МГТУ Московский государственный технический университет им. Н.Э. Баумана РГГУ Российский государственный гуманитарный университет РГУНиГ им. И.М. Губкина Российский государственный университет нефти и газа им. И.М. Губкина СПбГУ Санкт-Петербургский государственный университет ПМГМУ им. И.М. Сеченова Первый Московский государственный медицинский университет им. И.М.Сеченова ЮФУ Южный федеральный университет КубГУ Кубанский государственный университет РНИМУ им. Н.И. Пирогова Российский национальный исследовательский медицинский университет имени Н. И. Пирогова МГИМО Московский государственный институт международных отношений (Университет) МИД России МАИ Московский авиационный институт НИУ УдГУ Удмуртский государственный университет РАНХиГС Российская академия народного хозяйства и государственной службы при Президенте Российской Федерации ВГУ Воронежский государственный университет СПбПУ Санкт-Петербургский политехнический университет Петра Великого Горный университет Санкт-Петербургский Горный университет МосУ МВД РФ Московский университет Министерства внутренних дел Российской Федерации им. В.Я Кикотя СКФУ Северо-Кавказский федеральный университет МГЛУ Московский государственный лингвистический университет БГТУ ВОЕНМЕХ Балтийский государственный технический университет «ВОЕНМЕХ» имени Д. Ф. Устинова ДГТУ Донской государственный технический университет РЭУ им. Г. В. Плеханова Российский экономический университет имени Г.В. Плеханова ЮУрГУ Южно-Уральский государственный университет (национальный исследовательский университет) СПбГЭУ Санкт-Петербургский государственный экономический университет НИУ ВШЭ Высшая школа экономики НИУ МТУСИ Московский технический университет связи и информатики КНИТУ Казанский национальный исследовательский технологический университет ТюмГНГУ Тюменский государственный нефтегазовый университет (ныне Тюменский индустриальный университет) РУТ (МИИТ) Российский университет транспорта (МИИТ) СФУ Сибирский федеральный университет УГНТУ Уфимский государственный нефтяной технический университет ТюмГУ Тюменский государственный университет МПГУ Московский педагогический государственный университет МГПУ Московский городской педагогический университет ЛГУ им. Пушкина Ленинградский государственный университет имени А. С. Пушкина РГПУ Российский государственный педагогический университет имени А. И. Герцена СГУ им. Чернышевского Саратовский государственный университет имени Н.Г. Чернышевского РГСУ Российский государственный социальный университет НГТУ Новосибирский государственный технический университет ПГУ Пензенский государственный университет КубГАУ Кубанский государственный аграрный университет КубГТУ Кубанский государственный технологический университет ВУМО Военный университет Министерства обороны Российской Федерации Университет ИТМО Санкт-Петербургский национальный исследовательский университет информационных технологий, механики и оптики РГАУ-МСХА им. Тимирязева Российский государственный аграрный университет – МСХА имени К.А. Тимирязева ННГУ им. Лобачевского Нижегородский государственный университет им. Н.И. Лобачевского ПСПбГМУ им. Павлова Первый Санкт-Петербургский государственный медицинский университет имени академика И. П. Павлова СамГТУ Самарский государственный технический университет БелГУ Белгородский государственный национальный исследовательский университет РХТУ Российский химико-технологический университет им. Д.И. Менделеева ФУ Финансовый университет при Правительстве Российской Федерации МГМСУ им. А.И. Евдокимова Московский государственный медико-стоматологический университет БашГУ Башкирский государственный университет ОГУ Оренбургский государственный университет КГМУ Казанский государственный медицинский университет ИРНИТУ Иркутский национальный исследовательский технический университет МГХПА Московская государственная художественно-промышленная академия им. С. Г. Строганова Академия ФСБ Академия федеральной службы безопасности Российской Федерации СГАУ Самарский государственный аэрокосмический университет им. академика С.П. Королева (национальный исследовательский университет) САФУ Северный (Арктический) федеральный университет имени М.В. Ломоносова ВолГУ Волгоградский государственный университет ИГУ Иркутский государственный университет БФУ им. Канта Балтийский федеральный университет имени Иммануила Канта НИУ МГСУ Национальный исследовательский Московский государственный строительный университет УГАТУ Уфимский государственный авиационный технический университет АГЗ МЧС РФ Академия гражданской защиты МЧС России СПбГАСУ Санкт-Петербургский государственный архитектурно-строительный университет ВГАСУ Воронежский государственный архитектурно-строительный университет УрГПУ Уральский государственный педагогический университет ОмГУ Омский государственный университет им. Ф.М. Достоевского НИУ МИСиС Национальный исследовательский технологический университет «МИСиС» СГТУ Саратовский государственный технический университет им. Гагарина Ю.А. СамГУ Самарский государственный университет ОмГТУ Омский государственный технический университет НГМУ Новосибирский государственный медицинский университет КГАСУ Казанский государственный архитектурно-строительный университет МИРЭА, МГУПИ, МИТХТ Московский технологический университет ИжГТУ Ижевский государственный технический университет им. М.Т. Калашникова МГОУ Московский государственный областной университет НИУ МЭИ Национальный исследовательский университет «МЭИ» СПбУ МВД РФ Санкт-Петербургский университет Министерства внутренних дел РФ НГТУ им. Алексеева Нижегородский государственный технический университет им. Р.Е. Алексеева ДГУ Дагестанский государственный университет РГСУ Ростовский государственный строительный университет БГАУ Башкирский государственный аграрный университет МГУКИ Московский государственный университет культуры и искусств КубГМУ Кубанский государственный медицинский университет ВГТУ Воронежский государственный технический университет НГПУ Новосибирский государственный педагогический университет ВКА им. Можайского Военно-космическая академия имени А. Ф. Можайского ЧелГУ Челябинский государственный университет ТГУ Национальный исследовательский Томский государственный университет СГЮА Саратовская государственная юридическая академия МГППУ Московский государственный психолого-педагогический университет МГУТУ им. К.Г. Разумовского Московский государственный университет технологий и управления им. К.Г. Разумовского КемГУ Кемеровский государственный университет МГАХИ Московский государственный академический художественный институт им. В.И. Сурикова РГУПС Ростовский государственный университет путей сообщения ГУАП Санкт-Петербургский государственный университет аэрокосмического приборостроения КУ МВД РФ Краснодарский университет Министерства внутренних дел Российской Федерации МГЮА Московский государственный юридический университет имени О.Е. Кутафина СЗГМУ Северо-Западный государственный медицинский университет им. И. И. Мечникова АГУ Астраханский государственный университет КГЭУ Казанский государственный энергетический университет ЯрГУ Ярославский государственный университет имени П. Г. Демидова ВГПУ Воронежский государственный педагогический университет АлтГУ Алтайский государственный университет СПбГУТ Санкт-Петербургский государственный университет телекоммуникаций им. проф. М.А.Бонч-Бруевича СПбУГПС Санкт-Петербургский университет государственной противопожарной службы МЧС России РГЭУ (РИНХ) Ростовский государственный экономический университет (РИНХ) СПбУТУиЭ Санкт-Петербургский университет технологий управления и экономики ПГНИУ Пермский государственный национальный исследовательский университет УГЛТУ Уральский государственный лесотехнический университет РГУФКСМиТ Российский государственный университет физической культуры, спорта, молодежи и туризма ВГАУ Воронежский государственный аграрный университет им. императора Петра I ГУМРФ им. Макарова Государственный университет морского и речного флота имени адмирала С. О. Макарова МФТИ Московский физико-технический институт (Государственный университет) НГУ Новосибирский национальный исследовательский государственный университет РосНОУ Российский новый университет ВГУЭС Владивостокский государственный университет экономики и сервиса ВолгГМУ Волгоградский государственный медицинский университет РГУТиС Российский государственный университет туризма и сервиса НИЯУ МИФИ Национальный исследовательский ядерный университет «МИФИ» АлтГТУ Алтайский государственный технический университет им. И.И. Ползунова СПбГУГА Санкт-Петербургский государственный университет гражданской авиации ВятГУ Вятский государственный университет ПГУ Пятигорский государственный университет ОмГУПС Омский государственный университет путей сообщения СПбГЭТУ «ЛЭТИ» Санкт-Петербургский государственный электротехнический университет «ЛЭТИ» им. В.И. Ульянова (Ленина) ЯГПУ Ярославский государственный педагогический университет им. К.Д. Ушинского СамГМУ Самарский государственный медицинский университет СПбГАУ Санкт-Петербургский государственный аграрный университет МГТУ им. Носова Магнитогорский государственный технический университет им. Г.И. Носова БГПУ им. М. Акмуллы Башкирский государственный педагогический университет им. М. Акмуллы МФЮА Московский финансово-юридический университет СГМУ Саратовский государственный медицинский университет им. В.И. Разумовского ВИВВ МВД РФ Санкт-Петербургский военный институт внутренних войск МВД РФ КГИК Краснодарский государственный институт культуры РГППУ Российский государственный профессионально-педагогический университет МАДИ (ГТУ) Московский автомобильно-дорожный государственный технический университет АГТУ Астраханский государственный технический университет СПбГУП Санкт-Петербургский гуманитарный университет профсоюзов ОмГПУ Омский государственный педагогический университет ТПУ Национальный исследовательский Томский политехнический университет СПбГТИ Санкт-Петербургский государственный технологический институт (технический университет) МГАВМиБ им. К.И. Скрябина Московская государственная академия ветеринарной медицины и биотехнологии им. К.И. Скрябина УГМА Уральский государственный медицинский университет МАМИ Московский государственный машиностроительный университет ВГСПУ Волгоградский государственный социально-педагогический университет БГТУ им. В.Г. Шухова Белгородский государственный технологический университет им. В.Г. Шухова РостГМУ Ростовский государственный медицинский университет РТА Российская таможенная академия УрГЭУ Уральский государственный экономический университет ГУУ Государственный университет управления ВГУИТ Воронежский государственный университет инженерных технологий ВолгГТУ Волгоградский государственный технический университет СГАСУ Самарский государственный архитектурно-строительный университет ВАВТ Всероссийская академия внешней торговли Министерства экономического развития России ОрГМУ Оренбургская государственная медицинская академия ТГМУ Тихоокеанский государственный медицинский университет СибГТУ Сибирский государственный технологический университет ТюмГАСУ Тюменский государственный архитектурно-строительный университет СПбГТЭУ Санкт-Петербургский государственный торгово-экономический университет (часть СПбПУ) СПбГИК Санкт-Петербургский государственный институт культуры ЯГТУ Ярославский государственный технический университет Академия ФСИН Академия права и управления Федеральной службы исполнения наказаний ПГМУ Пермский государственный медицинский университет им. акад. Е.А. Вагнера КазГИК Казанский государственный институт культуры ДГПУ Дагестанский государственный педагогический университет СГУ Сочинский государственный университет СПбГЛТУ Санкт-Петербургский государственный лесотехнический университет им. С.М. Кирова ПГУПС Петербургский государственный университет путей сообщения императора Александра I УрГЮУ Уральский государственный юридический университет ННГАСУ Нижегородский государственный архитектурно-строительный университет ПНИПУ Пермский национальный исследовательский политехнический университет УГГУ Уральский государственный горный университет ЮРГПУ Южно-Российский государственный политехнический университет им. М.И. Платова ГУЗ Государственный университет по землеустройству РПА Минюста России Всероссийский государственный университет юстиции КрасГМУ Красноярский государственный медицинский университет им. проф. В.Ф. Войно-Ясенецкого НижГМА Нижегородская государственная медицинская академия Министерства здравоохранения и социального развития Российской Федерации УрГУПС Уральский государственный университет путей сообщения НГАУ Новосибирский государственный аграрный университет СГУПС Сибирский государственный университет путей сообщения РГУП Российский государственный университет правосудия РМАТ Российская международная академия туризма РАМ Российская академия музыки им. Гнесиных СПХФА Санкт-Петербургская государственная химико-фармацевтическая академия НА МВД РФ Нижегородская академия Министерства внутренних дел России КрасГАУ Красноярский государственный аграрный университет МАРХИ Московский архитектурный институт (Государственная академия) НГУЭУ Новосибирский государственный университет экономики и управления – “НИНХ” ВГИК Всероссийский государственный университет кинематографии имени С. А. Герасимова ЯГМУ Ярославский государственный медицинский университет РГУ Рязанский государственный университет им. С.А. Есенина АГМУ Алтайский государственный медицинский университет ГАУГН Государственный академический университет гуманитарных наук при Российской академии наук СПбГУПТД Санкт-Петербургский государственный университет промышленных технологий и дизайна СПбГПМУ Санкт-Петербургский государственный педиатрический медицинский университет ВолГАУ Волгоградский государственный аграрный университет СИ РАО Смольный институт Российской академии образования МГТУ “Станкин” Московский государственный технологический университет «Станкин» СибГМУ Сибирский государственный медицинский университет РязГМУ Рязанский государственный медицинский университет им. акад. И.П. Павлова ВАС им. Буденого Военная академия связи имени маршала Советского Союза С. М. Буденного МФПУ Синергия Университет СИНЕРГИЯ ДГМА Дагестанская государственная медицинская академия ВГМА им. Бурденко Воронежская государственная медицинская академия ПГГПУ Пермский государственный гуманитарно-педагогический университет СибГУТИ Сибирский государственный университет телекоммуникаций и информатики МГУЛ Московский государственный университет леса МГУДТ Московский государственный университет дизайна и технологии ВИ МВД РФ Воронежский институт МВД России КГПУ Красноярский государственный педагогический университет им. В.П. Астафьева МИЭТ Национальный исследовательский университет «МИЭТ» СмолГУ Смоленский государственный университет ИГМУ Иркутский государственный медицинский университет СГАУ Саратовский государственный аграрный университет им. Н.И. Вавилова МГУ Морской государственный университет им. адм. Г.И. Невельского АГАУ Алтайский государственный аграрный университет СПбГАВМ Санкт-Петербургская государственная академия ветеринарной медицины ГИТР Гуманитарный институт телевидения и радиовещания им. М.А. Литовчина ИЭУП Казанский инновационный университет имени В.Г. Тимитясова КузГТУ им. Горбачева Кузбасский государственный технический университет СибАДИ Сибирский государственный автомобильно-дорожный университет ТГУ Тольяттинский государственный университет СПбГМТУ Санкт-Петербургский государственный морской технический университет “Корабелка” СГЭУ Самарский государственный экономический университет Тюменский ГМУ Тюменский государственный медицинский университет ВИТИ Военный инженерно-технический институт Военной академии материально-технического обеспечения имени генерала армии А. В. Хрулева “ТИСБИ” Университет управления “ТИСБИ” СЮИ ФСИН РФ Самарский юридический институт ФСИН России МГТУГА Московский государственный технический университет гражданской авиации НГЛУ Нижегородский государственный лингвистический университет им. Н.А. Добролюбова БГУ Байкальский государственный университет МИИГАиК Московский государственный университет геодезии и картографии ИжГСХА Ижевская государственная сельскохозяйственная академия ВВА Военно-воздушная академия им. проф. Н.Е. Жуковского и Ю.А. Гагарина ИГМА Ижевская государственная медицинская академия РГРТУ Рязанский государственный радиотехнический университет УрГАУ Уральский государственный аграрный университет БГМУ Минздрава России Башкирский государственный медицинский университет НВВКУ Новосибирское высшее военное командное училище Университет «Дубна» Государственный университет «Дубна» КГТУ Калининградский государственный технический университет СГМУ Северный государственный медицинский университет ОмГМУ Омский государственный медицинский университет КГУФКСТ Кубанский государственный университет физической культуры, спорта и туризма УИ ГПС МЧС России Уральский институт Государственной противопожарной службы МЧС России КГАУ Казанский государственный аграрный университет БАТиП Балтийская академия туризма и предпринимательства Астраханский ГМУ Астраханский государственный медицинский университет ТГИК Тюменский государственный институт культуры СИБУПК Сибирский университет потребительской кооперации МИТХТ Московский государственный университет тонких химических технологий имени М.В. Ломоносова Поволжская ГАФКСиТ Поволжская государственная академия физической культуры, спорта и туризма ВАМТО Военная академия материально-технического обеспечения им. генерала армии А.В. Хрулёва ГИТИС Российский институт театрального искусства КГМА Кировская государственная медицинская академия ВГУВТ Волжский государственный университет водного транспорта СтГАУ Ставропольский государственный аграрный университет РГГМУ Российский государственный гидрометеорологический университет ВИ ФСИН Воронежский институт федеральной службы исполнения наказаний Российской Федерации СПбГИКиТ Санкт-Петербургский государственный институт кино и телевидения ОГПУ Оренбургский государственный педагогический университет ОГАУ Оренбургский государственный аграрный университет НГПУ Нижегородский государственный педагогический университет им. Козьмы Минина ОГИС Омский государственный институт сервиса РАЖВиЗ Российская академия живописи, ваяния и зодчества Ильи Глазунова АГПА Армавирская государственная педагогическая академия НВИ ВВ МВД РФ Новосибирский военный институт внутренних войск МВД России имени генерала армии И.К. Яковлева ТУСУР Томский государственный университет систем управления и радиоэлектроники НГСХА Нижегородская государственная сельскохозяйственная академия МПИ ФСБ РФ Московский пограничный институт Федеральной службы безопасности Российской Федерации Филиал РАНХиГС в Санкт-Петербурге Северо-Западный институт управления РАНХиГС НЧФ КФУ Набережночелнинский институт КФУ (филиал) ТГАСУ Томский государственный архитектурно-строительный университет МГУП Московский государственный университет печати им. Ивана Федорова Московский политех Московский политехнический университет МосГУ Московский гуманитарный университет АлтГПУ Алтайский государственный педагогический университет СтГМУ Ставропольский государственный медицинский университет НИУ ВШЭ Санкт-Петербург Санкт-Петербургский кампус Национального исследовательского университета «Высшая школа экономики» ВА МВД РФ Волгоградская академия МВД России Академия ГПС МЧС России Академия государственной противопожарной службы Министерства Российской Федерации по делам гражданской обороны, чрезвычайным ситуациям и ликвидации последствий стихийных бедствий ВМА им. Кузнецова Военно-морская академия имени адмирала флота Советского Союза Н. Г. Кузнецова МВАА Михайловская военная артиллерийская академия ОмГАУ Омский государственнvuzopedia.ru
Вузы Москвы 2018 с ЕГЭ по биологии: специальности. Куда поступать?
closeДобавить вуз в сравнение
МГУ Московский государственный университет имени М.В. Ломоносова КФУ Казанский (Приволжский) федеральный университет УрФУ Уральский федеральный университет имени первого Президента России Б. Н. Ельцина РУДН Российский университет дружбы народов ДВФУ Дальневосточный федеральный университет МГТУ Московский государственный технический университет им. Н.Э. Баумана РГГУ Российский государственный гуманитарный университет РГУНиГ им. И.М. Губкина Российский государственный университет нефти и газа им. И.М. Губкина СПбГУ Санкт-Петербургский государственный университет ПМГМУ им. И.М. Сеченова Первый Московский государственный медицинский университет им. И.М.Сеченова ЮФУ Южный федеральный университет КубГУ Кубанский государственный университет РНИМУ им. Н.И. Пирогова Российский национальный исследовательский медицинский университет имени Н. И. Пирогова МГИМО Московский государственный институт международных отношений (Университет) МИД России МАИ Московский авиационный институт НИУ УдГУ Удмуртский государственный университет РАНХиГС Российская академия народного хозяйства и государственной службы при Президенте Российской Федерации ВГУ Воронежский государственный университет СПбПУ Санкт-Петербургский политехнический университет Петра Великого Горный университет Санкт-Петербургский Горный университет МосУ МВД РФ Московский университет Министерства внутренних дел Российской Федерации им. В.Я Кикотя СКФУ Северо-Кавказский федеральный университет МГЛУ Московский государственный лингвистический университет БГТУ ВОЕНМЕХ Балтийский государственный технический университет «ВОЕНМЕХ» имени Д. Ф. Устинова ДГТУ Донской государственный технический университет РЭУ им. Г. В. Плеханова Российский экономический университет имени Г.В. Плеханова ЮУрГУ Южно-Уральский государственный университет (национальный исследовательский университет) СПбГЭУ Санкт-Петербургский государственный экономический университет НИУ ВШЭ Высшая школа экономики НИУ МТУСИ Московский технический университет связи и информатики КНИТУ Казанский национальный исследовательский технологический университет ТюмГНГУ Тюменский государственный нефтегазовый университет (ныне Тюменский индустриальный университет) РУТ (МИИТ) Российский университет транспорта (МИИТ) СФУ Сибирский федеральный университет УГНТУ Уфимский государственный нефтяной технический университет ТюмГУ Тюменский государственный университет МПГУ Московский педагогический государственный университет МГПУ Московский городской педагогический университет ЛГУ им. Пушкина Ленинградский государственный университет имени А. С. Пушкина РГПУ Российский государственный педагогический университет имени А. И. Герцена СГУ им. Чернышевского Саратовский государственный университет имени Н.Г. Чернышевского РГСУ Российский государственный социальный университет НГТУ Новосибирский государственный технический университет ПГУ Пензенский государственный университет КубГАУ Кубанский государственный аграрный университет КубГТУ Кубанский государственный технологический университет ВУМО Военный университет Министерства обороны Российской Федерации Университет ИТМО Санкт-Петербургский национальный исследовательский университет информационных технологий, механики и оптики РГАУ-МСХА им. Тимирязева Российский государственный аграрный университет – МСХА имени К.А. Тимирязева ННГУ им. Лобачевского Нижегородский государственный университет им. Н.И. Лобачевского ПСПбГМУ им. Павлова Первый Санкт-Петербургский государственный медицинский университет имени академика И. П. Павлова СамГТУ Самарский государственный технический университет БелГУ Белгородский государственный национальный исследовательский университет РХТУ Российский химико-технологический университет им. Д.И. Менделеева ФУ Финансовый университет при Правительстве Российской Федерации МГМСУ им. А.И. Евдокимова Московский государственный медико-стоматологический университет БашГУ Башкирский государственный университет ОГУ Оренбургский государственный университет КГМУ Казанский государственный медицинский университет ИРНИТУ Иркутский национальный исследовательский технический университет МГХПА Московская государственная художественно-промышленная академия им. С. Г. Строганова Академия ФСБ Академия федеральной службы безопасности Российской Федерации СГАУ Самарский государственный аэрокосмический университет им. академика С.П. Королева (национальный исследовательский университет) САФУ Северный (Арктический) федеральный университет имени М.В. Ломоносова ВолГУ Волгоградский государственный университет ИГУ Иркутский государственный университет БФУ им. Канта Балтийский федеральный университет имени Иммануила Канта НИУ МГСУ Национальный исследовательский Московский государственный строительный университет УГАТУ Уфимский государственный авиационный технический университет АГЗ МЧС РФ Академия гражданской защиты МЧС России СПбГАСУ Санкт-Петербургский государственный архитектурно-строительный университет ВГАСУ Воронежский государственный архитектурно-строительный университет УрГПУ Уральский государственный педагогический университет ОмГУ Омский государственный университет им. Ф.М. Достоевского НИУ МИСиС Национальный исследовательский технологический университет «МИСиС» СГТУ Саратовский государственный технический университет им. Гагарина Ю.А. СамГУ Самарский государственный университет ОмГТУ Омский государственный технический университет НГМУ Новосибирский государственный медицинский университет КГАСУ Казанский государственный архитектурно-строительный университет МИРЭА, МГУПИ, МИТХТ Московский технологический университет ИжГТУ Ижевский государственный технический университет им. М.Т. Калашникова МГОУ Московский государственный областной университет НИУ МЭИ Национальный исследовательский университет «МЭИ» СПбУ МВД РФ Санкт-Петербургский университет Министерства внутренних дел РФ НГТУ им. Алексеева Нижегородский государственный технический университет им. Р.Е. Алексеева ДГУ Дагестанский государственный университет РГСУ Ростовский государственный строительный университет БГАУ Башкирский государственный аграрный университет МГУКИ Московский государственный университет культуры и искусств КубГМУ Кубанский государственный медицинский университет ВГТУ Воронежский государственный технический университет НГПУ Новосибирский государственный педагогический университет ВКА им. Можайского Военно-космическая академия имени А. Ф. Можайского ЧелГУ Челябинский государственный университет ТГУ Национальный исследовательский Томский государственный университет СГЮА Саратовская государственная юридическая академия МГППУ Московский государственный психолого-педагогический университет МГУТУ им. К.Г. Разумовского Московский государственный университет технологий и управления им. К.Г. Разумовского КемГУ Кемеровский государственный университет МГАХИ Московский государственный академический художественный институт им. В.И. Сурикова РГУПС Ростовский государственный университет путей сообщения ГУАП Санкт-Петербургский государственный университет аэрокосмического приборостроения КУ МВД РФ Краснодарский университет Министерства внутренних дел Российской Федерации МГЮА Московский государственный юридический университет имени О.Е. Кутафина СЗГМУ Северо-Западный государственный медицинский университет им. И. И. Мечникова АГУ Астраханский государственный университет КГЭУ Казанский государственный энергетический университет ЯрГУ Ярославский государственный университет имени П. Г. Демидова ВГПУ Воронежский государственный педагогический университет АлтГУ Алтайский государственный университет СПбГУТ Санкт-Петербургский государственный университет телекоммуникаций им. проф. М.А.Бонч-Бруевича СПбУГПС Санкт-Петербургский университет государственной противопожарной службы МЧС России РГЭУ (РИНХ) Ростовский государственный экономический университет (РИНХ) СПбУТУиЭ Санкт-Петербургский университет технологий управления и экономики ПГНИУ Пермский государственный национальный исследовательский университет УГЛТУ Уральский государственный лесотехнический университет РГУФКСМиТ Российский государственный университет физической культуры, спорта, молодежи и туризма ВГАУ Воронежский государственный аграрный университет им. императора Петра I ГУМРФ им. Макарова Государственный университет морского и речного флота имени адмирала С. О. Макарова МФТИ Московский физико-технический институт (Государственный университет) НГУ Новосибирский национальный исследовательский государственный университет РосНОУ Российский новый университет ВГУЭС Владивостокский государственный университет экономики и сервиса ВолгГМУ Волгоградский государственный медицинский университет РГУТиС Российский государственный университет туризма и сервиса НИЯУ МИФИ Национальный исследовательский ядерный университет «МИФИ» АлтГТУ Алтайский государственный технический университет им. И.И. Ползунова СПбГУГА Санкт-Петербургский государственный университет гражданской авиации ВятГУ Вятский государственный университет ПГУ Пятигорский государственный университет ОмГУПС Омский государственный университет путей сообщения СПбГЭТУ «ЛЭТИ» Санкт-Петербургский государственный электротехнический университет «ЛЭТИ» им. В.И. Ульянова (Ленина) ЯГПУ Ярославский государственный педагогический университет им. К.Д. Ушинского СамГМУ Самарский государственный медицинский университет СПбГАУ Санкт-Петербургский государственный аграрный университет МГТУ им. Носова Магнитогорский государственный технический университет им. Г.И. Носова БГПУ им. М. Акмуллы Башкирский государственный педагогический университет им. М. Акмуллы МФЮА Московский финансово-юридический университет СГМУ Саратовский государственный медицинский университет им. В.И. Разумовского ВИВВ МВД РФ Санкт-Петербургский военный институт внутренних войск МВД РФ КГИК Краснодарский государственный институт культуры РГППУ Российский государственный профессионально-педагогический университет МАДИ (ГТУ) Московский автомобильно-дорожный государственный технический университет АГТУ Астраханский государственный технический университет СПбГУП Санкт-Петербургский гуманитарный университет профсоюзов ОмГПУ Омский государственный педагогический университет ТПУ Национальный исследовательский Томский политехнический университет СПбГТИ Санкт-Петербургский государственный технологический институт (технический университет) МГАВМиБ им. К.И. Скрябина Московская государственная академия ветеринарной медицины и биотехнологии им. К.И. Скрябина УГМА Уральский государственный медицинский университет МАМИ Московский государственный машиностроительный университет ВГСПУ Волгоградский государственный социально-педагогический университет БГТУ им. В.Г. Шухова Белгородский государственный технологический университет им. В.Г. Шухова РостГМУ Ростовский государственный медицинский университет РТА Российская таможенная академия УрГЭУ Уральский государственный экономический университет ГУУ Государственный университет управления ВГУИТ Воронежский государственный университет инженерных технологий ВолгГТУ Волгоградский государственный технический университет СГАСУ Самарский государственный архитектурно-строительный университет ВАВТ Всероссийская академия внешней торговли Министерства экономического развития России ОрГМУ Оренбургская государственная медицинская академия ТГМУ Тихоокеанский государственный медицинский университет СибГТУ Сибирский государственный технологический университет ТюмГАСУ Тюменский государственный архитектурно-строительный университет СПбГТЭУ Санкт-Петербургский государственный торгово-экономический университет (часть СПбПУ) СПбГИК Санкт-Петербургский государственный институт культуры ЯГТУ Ярославский государственный технический университет Академия ФСИН Академия права и управления Федеральной службы исполнения наказаний ПГМУ Пермский государственный медицинский университет им. акад. Е.А. Вагнера КазГИК Казанский государственный институт культуры ДГПУ Дагестанский государственный педагогический университет СГУ Сочинский государственный университет СПбГЛТУ Санкт-Петербургский государственный лесотехнический университет им. С.М. Кирова ПГУПС Петербургский государственный университет путей сообщения императора Александра I УрГЮУ Уральский государственный юридический университет ННГАСУ Нижегородский государственный архитектурно-строительный университет ПНИПУ Пермский национальный исследовательский политехнический университет УГГУ Уральский государственный горный университет ЮРГПУ Южно-Российский государственный политехнический университет им. М.И. Платова ГУЗ Государственный университет по землеустройству РПА Минюста России Всероссийский государственный университет юстиции КрасГМУ Красноярский государственный медицинский университет им. проф. В.Ф. Войно-Ясенецкого НижГМА Нижегородская государственная медицинская академия Министерства здравоохранения и социального развития Российской Федерации УрГУПС Уральский государственный университет путей сообщения НГАУ Новосибирский государственный аграрный университет СГУПС Сибирский государственный университет путей сообщения РГУП Российский государственный университет правосудия РМАТ Российская международная академия туризма РАМ Российская академия музыки им. Гнесиных СПХФА Санкт-Петербургская государственная химико-фармацевтическая академия НА МВД РФ Нижегородская академия Министерства внутренних дел России КрасГАУ Красноярский государственный аграрный университет МАРХИ Московский архитектурный институт (Государственная академия) НГУЭУ Новосибирский государственный университет экономики и управления – “НИНХ” ВГИК Всероссийский государственный университет кинематографии имени С. А. Герасимова ЯГМУ Ярославский государственный медицинский университет РГУ Рязанский государственный университет им. С.А. Есенина АГМУ Алтайский государственный медицинский университет ГАУГН Государственный академический университет гуманитарных наук при Российской академии наук СПбГУПТД Санкт-Петербургский государственный университет промышленных технологий и дизайна СПбГПМУ Санкт-Петербургский государственный педиатрический медицинский университет ВолГАУ Волгоградский государственный аграрный университет СИ РАО Смольный институт Российской академии образования МГТУ “Станкин” Московский государственный технологический университет «Станкин» СибГМУ Сибирский государственный медицинский университет РязГМУ Рязанский государственный медицинский университет им. акад. И.П. Павлова ВАС им. Буденого Военная академия связи имени маршала Советского Союза С. М. Буденного МФПУ Синергия Университет СИНЕРГИЯ ДГМА Дагестанская государственная медицинская академия ВГМА им. Бурденко Воронежская государственная медицинская академия ПГГПУ Пермский государственный гуманитарно-педагогический университет СибГУТИ Сибирский государственный университет телекоммуникаций и информатики МГУЛ Московский государственный университет леса МГУДТ Московский государственный университет дизайна и технологии ВИ МВД РФ Воронежский институт МВД России КГПУ Красноярский государственный педагогический университет им. В.П. Астафьева МИЭТ Национальный исследовательский университет «МИЭТ» СмолГУ Смоленский государственный университет ИГМУ Иркутский государственный медицинский университет СГАУ Саратовский государственный аграрный университет им. Н.И. Вавилова МГУ Морской государственный университет им. адм. Г.И. Невельского АГАУ Алтайский государственный аграрный университет СПбГАВМ Санкт-Петербургская государственная академия ветеринарной медицины ГИТР Гуманитарный институт телевидения и радиовещания им. М.А. Литовчина ИЭУП Казанский инновационный университет имени В.Г. Тимитясова КузГТУ им. Горбачева Кузбасский государственный технический университет СибАДИvuzopedia.ru
Вузы Иркутска 2018 с ЕГЭ по биологии: специальности. Куда поступать?
closeДобавить вуз в сравнение
МГУ Московский государственный университет имени М.В. Ломоносова КФУ Казанский (Приволжский) федеральный университет УрФУ Уральский федеральный университет имени первого Президента России Б. Н. Ельцина РУДН Российский университет дружбы народов ДВФУ Дальневосточный федеральный университет МГТУ Московский государственный технический университет им. Н.Э. Баумана РГГУ Российский государственный гуманитарный университет РГУНиГ им. И.М. Губкина Российский государственный университет нефти и газа им. И.М. Губкина СПбГУ Санкт-Петербургский государственный университет ПМГМУ им. И.М. Сеченова Первый Московский государственный медицинский университет им. И.М.Сеченова ЮФУ Южный федеральный университет КубГУ Кубанский государственный университет РНИМУ им. Н.И. Пирогова Российский национальный исследовательский медицинский университет имени Н. И. Пирогова МГИМО Московский государственный институт международных отношений (Университет) МИД России МАИ Московский авиационный институт НИУ УдГУ Удмуртский государственный университет РАНХиГС Российская академия народного хозяйства и государственной службы при Президенте Российской Федерации ВГУ Воронежский государственный университет СПбПУ Санкт-Петербургский политехнический университет Петра Великого Горный университет Санкт-Петербургский Горный университет МосУ МВД РФ Московский университет Министерства внутренних дел Российской Федерации им. В.Я Кикотя СКФУ Северо-Кавказский федеральный университет МГЛУ Московский государственный лингвистический университет БГТУ ВОЕНМЕХ Балтийский государственный технический университет «ВОЕНМЕХ» имени Д. Ф. Устинова ДГТУ Донской государственный технический университет РЭУ им. Г. В. Плеханова Российский экономический университет имени Г.В. Плеханова ЮУрГУ Южно-Уральский государственный университет (национальный исследовательский университет) СПбГЭУ Санкт-Петербургский государственный экономический университет НИУ ВШЭ Высшая школа экономики НИУ МТУСИ Московский технический университет связи и информатики КНИТУ Казанский национальный исследовательский технологический университет ТюмГНГУ Тюменский государственный нефтегазовый университет (ныне Тюменский индустриальный университет) РУТ (МИИТ) Российский университет транспорта (МИИТ) СФУ Сибирский федеральный университет УГНТУ Уфимский государственный нефтяной технический университет ТюмГУ Тюменский государственный университет МПГУ Московский педагогический государственный университет МГПУ Московский городской педагогический университет ЛГУ им. Пушкина Ленинградский государственный университет имени А. С. Пушкина РГПУ Российский государственный педагогический университет имени А. И. Герцена СГУ им. Чернышевского Саратовский государственный университет имени Н.Г. Чернышевского РГСУ Российский государственный социальный университет НГТУ Новосибирский государственный технический университет ПГУ Пензенский государственный университет КубГАУ Кубанский государственный аграрный университет КубГТУ Кубанский государственный технологический университет ВУМО Военный университет Министерства обороны Российской Федерации Университет ИТМО Санкт-Петербургский национальный исследовательский университет информационных технологий, механики и оптики РГАУ-МСХА им. Тимирязева Российский государственный аграрный университет – МСХА имени К.А. Тимирязева ННГУ им. Лобачевского Нижегородский государственный университет им. Н.И. Лобачевского ПСПбГМУ им. Павлова Первый Санкт-Петербургский государственный медицинский университет имени академика И. П. Павлова СамГТУ Самарский государственный технический университет БелГУ Белгородский государственный национальный исследовательский университет РХТУ Российский химико-технологический университет им. Д.И. Менделеева ФУ Финансовый университет при Правительстве Российской Федерации МГМСУ им. А.И. Евдокимова Московский государственный медико-стоматологический университет БашГУ Башкирский государственный университет ОГУ Оренбургский государственный университет КГМУ Казанский государственный медицинский университет ИРНИТУ Иркутский национальный исследовательский технический университет МГХПА Московская государственная художественно-промышленная академия им. С. Г. Строганова Академия ФСБ Академия федеральной службы безопасности Российской Федерации СГАУ Самарский государственный аэрокосмический университет им. академика С.П. Королева (национальный исследовательский университет) САФУ Северный (Арктический) федеральный университет имени М.В. Ломоносова ВолГУ Волгоградский государственный университет ИГУ Иркутский государственный университет БФУ им. Канта Балтийский федеральный университет имени Иммануила Канта НИУ МГСУ Национальный исследовательский Московский государственный строительный университет УГАТУ Уфимский государственный авиационный технический университет АГЗ МЧС РФ Академия гражданской защиты МЧС России СПбГАСУ Санкт-Петербургский государственный архитектурно-строительный университет ВГАСУ Воронежский государственный архитектурно-строительный университет УрГПУ Уральский государственный педагогический университет ОмГУ Омский государственный университет им. Ф.М. Достоевского НИУ МИСиС Национальный исследовательский технологический университет «МИСиС» СГТУ Саратовский государственный технический университет им. Гагарина Ю.А. СамГУ Самарский государственный университет ОмГТУ Омский государственный технический университет НГМУ Новосибирский государственный медицинский университет КГАСУ Казанский государственный архитектурно-строительный университет МИРЭА, МГУПИ, МИТХТ Московский технологический университет ИжГТУ Ижевский государственный технический университет им. М.Т. Калашникова МГОУ Московский государственный областной университет НИУ МЭИ Национальный исследовательский университет «МЭИ» СПбУ МВД РФ Санкт-Петербургский университет Министерства внутренних дел РФ НГТУ им. Алексеева Нижегородский государственный технический университет им. Р.Е. Алексеева ДГУ Дагестанский государственный университет РГСУ Ростовский государственный строительный университет БГАУ Башкирский государственный аграрный университет МГУКИ Московский государственный университет культуры и искусств КубГМУ Кубанский государственный медицинский университет ВГТУ Воронежский государственный технический университет НГПУ Новосибирский государственный педагогический университет ВКА им. Можайского Военно-космическая академия имени А. Ф. Можайского ЧелГУ Челябинский государственный университет ТГУ Национальный исследовательский Томский государственный университет СГЮА Саратовская государственная юридическая академия МГППУ Московский государственный психолого-педагогический университет МГУТУ им. К.Г. Разумовского Московский государственный университет технологий и управления им. К.Г. Разумовского КемГУ Кемеровский государственный университет МГАХИ Московский государственный академический художественный институт им. В.И. Сурикова РГУПС Ростовский государственный университет путей сообщения ГУАП Санкт-Петербургский государственный университет аэрокосмического приборостроения КУ МВД РФ Краснодарский университет Министерства внутренних дел Российской Федерации МГЮА Московский государственный юридический университет имени О.Е. Кутафина СЗГМУ Северо-Западный государственный медицинский университет им. И. И. Мечникова АГУ Астраханский государственный университет КГЭУ Казанский государственный энергетический университет ЯрГУ Ярославский государственный университет имени П. Г. Демидова ВГПУ Воронежский государственный педагогический университет АлтГУ Алтайский государственный университет СПбГУТ Санкт-Петербургский государственный университет телекоммуникаций им. проф. М.А.Бонч-Бруевича СПбУГПС Санкт-Петербургский университет государственной противопожарной службы МЧС России РГЭУ (РИНХ) Ростовский государственный экономический университет (РИНХ) СПбУТУиЭ Санкт-Петербургский университет технологий управления и экономики ПГНИУ Пермский государственный национальный исследовательский университет УГЛТУ Уральский государственный лесотехнический университет РГУФКСМиТ Российский государственный университет физической культуры, спорта, молодежи и туризма ВГАУ Воронежский государственный аграрный университет им. императора Петра I ГУМРФ им. Макарова Государственный университет морского и речного флота имени адмирала С. О. Макарова МФТИ Московский физико-технический институт (Государственный университет) НГУ Новосибирский национальный исследовательский государственный университет РосНОУ Российский новый университет ВГУЭС Владивостокский государственный университет экономики и сервиса ВолгГМУ Волгоградский государственный медицинский университет РГУТиС Российский государственный университет туризма и сервиса НИЯУ МИФИ Национальный исследовательский ядерный университет «МИФИ» АлтГТУ Алтайский государственный технический университет им. И.И. Ползунова СПбГУГА Санкт-Петербургский государственный университет гражданской авиации ВятГУ Вятский государственный университет ПГУ Пятигорский государственный университет ОмГУПС Омский государственный университет путей сообщения СПбГЭТУ «ЛЭТИ» Санкт-Петербургский государственный электротехнический университет «ЛЭТИ» им. В.И. Ульянова (Ленина) ЯГПУ Ярославский государственный педагогический университет им. К.Д. Ушинского СамГМУ Самарский государственный медицинский университет СПбГАУ Санкт-Петербургский государственный аграрный университет МГТУ им. Носова Магнитогорский государственный технический университет им. Г.И. Носова БГПУ им. М. Акмуллы Башкирский государственный педагогический университет им. М. Акмуллы МФЮА Московский финансово-юридический университет СГМУ Саратовский государственный медицинский университет им. В.И. Разумовского ВИВВ МВД РФ Санкт-Петербургский военный институт внутренних войск МВД РФ КГИК Краснодарский государственный институт культуры РГППУ Российский государственный профессионально-педагогический университет МАДИ (ГТУ) Московский автомобильно-дорожный государственный технический университет АГТУ Астраханский государственный технический университет СПбГУП Санкт-Петербургский гуманитарный университет профсоюзов ОмГПУ Омский государственный педагогический университет ТПУ Национальный исследовательский Томский политехнический университет СПбГТИ Санкт-Петербургский государственный технологический институт (технический университет) МГАВМиБ им. К.И. Скрябина Московская государственная академия ветеринарной медицины и биотехнологии им. К.И. Скрябина УГМА Уральский государственный медицинский университет МАМИ Московский государственный машиностроительный университет ВГСПУ Волгоградский государственный социально-педагогический университет БГТУ им. В.Г. Шухова Белгородский государственный технологический университет им. В.Г. Шухова РостГМУ Ростовский государственный медицинский университет РТА Российская таможенная академия УрГЭУ Уральский государственный экономический университет ГУУ Государственный университет управления ВГУИТ Воронежский государственный университет инженерных технологий ВолгГТУ Волгоградский государственный технический университет СГАСУ Самарский государственный архитектурно-строительный университет ВАВТ Всероссийская академия внешней торговли Министерства экономического развития России ОрГМУ Оренбургская государственная медицинская академия ТГМУ Тихоокеанский государственный медицинский университет СибГТУ Сибирский государственный технологический университет ТюмГАСУ Тюменский государственный архитектурно-строительный университет СПбГТЭУ Санкт-Петербургский государственный торгово-экономический университет (часть СПбПУ) СПбГИК Санкт-Петербургский государственный институт культуры ЯГТУ Ярославский государственный технический университет Академия ФСИН Академия права и управления Федеральной службы исполнения наказаний ПГМУ Пермский государственный медицинский университет им. акад. Е.А. Вагнера КазГИК Казанский государственный институт культуры ДГПУ Дагестанский государственный педагогический университет СГУ Сочинский государственный университет СПбГЛТУ Санкт-Петербургский государственный лесотехнический университет им. С.М. Кирова ПГУПС Петербургский государственный университет путей сообщения императора Александра I УрГЮУ Уральский государственный юридический университет ННГАСУ Нижегородский государственный архитектурно-строительный университет ПНИПУ Пермский национальный исследовательский политехнический университет УГГУ Уральский государственный горный университет ЮРГПУ Южно-Российский государственный политехнический университет им. М.И. Платова ГУЗ Государственный университет по землеустройству РПА Минюста России Всероссийский государственный университет юстиции КрасГМУ Красноярский государственный медицинский университет им. проф. В.Ф. Войно-Ясенецкого НижГМА Нижегородская государственная медицинская академия Министерства здравоохранения и социального развития Российской Федерации УрГУПС Уральский государственный университет путей сообщения НГАУ Новосибирский государственный аграрный университет СГУПС Сибирский государственный университет путей сообщения РГУП Российский государственный университет правосудия РМАТ Российская международная академия туризма РАМ Российская академия музыки им. Гнесиных СПХФА Санкт-Петербургская государственная химико-фармацевтическая академия НА МВД РФ Нижегородская академия Министерства внутренних дел России КрасГАУ Красноярский государственный аграрный университет МАРХИ Московский архитектурный институт (Государственная академия) НГУЭУ Новосибирский государственный университет экономики и управления – “НИНХ” ВГИК Всероссийский государственный университет кинематографии имени С. А. Герасимова ЯГМУ Ярославский государственный медицинский университет РГУ Рязанский государственный университет им. С.А. Есенина АГМУ Алтайский государственный медицинский университет ГАУГН Государственный академический университет гуманитарных наук при Российской академии наук СПбГУПТД Санкт-Петербургский государственный университет промышленных технологий и дизайна СПбГПМУ Санкт-Петербургский государственный педиатрический медицинский университет ВолГАУ Волгоградский государственный аграрный университет СИ РАО Смольный институт Российской академии образования МГТУ “Станкин” Московский государственный технологический университет «Станкин» СибГМУ Сибирский государственный медицинский университет РязГМУ Рязанский государственный медицинский университет им. акад. И.П. Павлова ВАС им. Буденого Военная академия связи имени маршала Советского Союза С. М. Буденного МФПУ Синергия Университет СИНЕРГИЯ ДГМА Дагестанская государственная медицинская академия ВГМА им. Бурденко Воронежская государственная медицинская академия ПГГПУ Пермский государственный гуманитарно-педагогический университет СибГУТИ Сибирский государственный университет телекоммуникаций и информатики МГУЛ Московский государственный университет леса МГУДТ Московский государственный университет дизайна и технологии ВИ МВД РФ Воронежский институт МВД России КГПУ Красноярский государственный педагогический университет им. В.П. Астафьева МИЭТ Национальный исследовательский университет «МИЭТ» СмолГУ Смоленский государственный университет ИГМУ Иркутский государственный медицинский университет СГАУ Саратовский государственный аграрный университет им. Н.И. Вавилова МГУ Морской государственный университет им. адм. Г.И. Невельского АГАУ Алтайский государственный аграрный университет СПбГАВМ Санкт-Петербургская государственная академия ветеринарной медицины ГИТР Гуманитарный институт телевидения и радиовещания им. М.А. Литовчина ИЭУП Казанский инновационный университет имени В.Г. Тимитясова КузГТУ им. Горбачева Кузбасский государственный технический университет СибАДИ Сибирский государственный автомобильно-дорожный университет ТГУ Тольяттинский государственный университет СПбГМТУ Санкт-Петербургский государственный морской технический университет “Корабелка” СГЭУ Самарский государственный экономический университет Тюменский ГМУ Тюменский государственный медицинский университет ВИТИ Военный инженерно-технический институт Военной академии материально-технического обеспечения имени генерала армии А. В. Хрулева “ТИСБИ” Университет управления “ТИСБИ” СЮИ ФСИН РФ Самарский юридический институт ФСИН России МГТУГА Московский государственный технический университет гражданской авиации НГЛУ Нижегородский государственный лингвистический университет им. Н.А. Добролюбова БГУ Байкальский государственный университет МИИГАиК Московский государственный университет геодезии и картографии ИжГСХА Ижевская государственная сельскохозяйственная академия ВВА Военно-воздушная академия им. проф. Н.Е. Жуковского и Ю.А. Гагарина ИГМА Ижевская государственная медицинская академия РГРТУ Рязанский государственный радиотехнический университет УрГАУ Уральский государственный аграрный университет БГМУ Минздрава России Башкирский государственный медицинский университет НВВКУ Новосибирское высшее военное командное училище Университет «Дубна» Государственный университет «Дубна» КГТУ Калининградский государственный технический университет СГМУ Северный государственный медицинский университет ОмГМУ Омский государственный медицинский университет КГУФКСТ Кубанский государственный университет физической культуры, спорта и туризма УИ ГПС МЧС России Уральский институт Государственной противопожарной службы МЧС России КГАУ Казанский государственный аграрный университет БАТиП Балтийская академия туризма и предпринимательства Астраханский ГМУ Астраханский государственный медицинский университет ТГИК Тюменский государственный институт культуры СИБУПК Сибирский университет потребительской кооперации МИТХТ Московский государственный университет тонких химических технологий имени М.В. Ломоносова Поволжская ГАФКСиТ Поволжская государственная академия физической культуры, спорта и туризма ВАМТО Военная академия материально-технического обеспечения им. генерала армии А.В. Хрулёва ГИТИС Российский институт театрального искусства КГМА Кировская государственная медицинская академия ВГУВТ Волжский государственный университет водного транспорта СтГАУ Ставропольский государственный аграрный университет РГГМУ Российский государственный гидрометеорологический университет ВИ ФСИН Воронежский институт федеральной службы исполнения наказаний Российской Федерации СПбГИКиТ Санкт-Петербургский государственный институт кино и телевидения ОГПУ Оренбургский государственный педагогический университет ОГАУ Оренбургский государственный аграрный университет НГПУ Нижегородский государственный педагогический университет им. Козьмы Минина ОГИС Омский государственный институт сервиса РАЖВиЗ Российская академия живописи, ваяния и зодчества Ильи Глазунова АГПА Армавирская государственная педагогическая академия НВИ ВВ МВД РФ Новосибирский военный институт внутренних войск МВД России имени генерала армии И.К. Яковлева ТУСУР Томский государственный университет систем управления и радиоэлектроники НГСХА Нижегородская государственная сельскохозяйственная академия МПИ ФСБ РФ Московский пограничный институт Федеральной службы безопасности Российской Федерации Филиал РАНХиГС в Санкт-Петербурге Северо-Западный институт управления РАНХиГС НЧФ КФУ Набережночелнинский институт КФУ (филиал) ТГАСУ Томский государственный архитектурно-строительный университет МГУП Московский государственный университет печати им. Ивана Федорова Московский политех Московский политехнический университет МосГУ Московский гуманитарный университет АлтГПУ Алтайский государственный педагогический университет СтГМУ Ставропольский государственный медицинский университет НИУ ВШЭ Санкт-Петербург Санкт-Петербургский кампус Национального исследовательского университета «Высшая школа экономики» ВА МВД РФ Волгоградская академия МВД России Академия ГПС МЧС России Академия государственной противопожарной службы Министерства Российской Федерации по делам гражданской обороны, чрезвычайным ситуациям и ликвидации последствий стихийных бедствий ВМА им. Кузнецова Военно-морская академия имени адмирала флота Советского Союза Н. Г. Кузнецова МВАА Михайловская военная артиллерийская академия ОмГАУ Омский гvuzopedia.ru